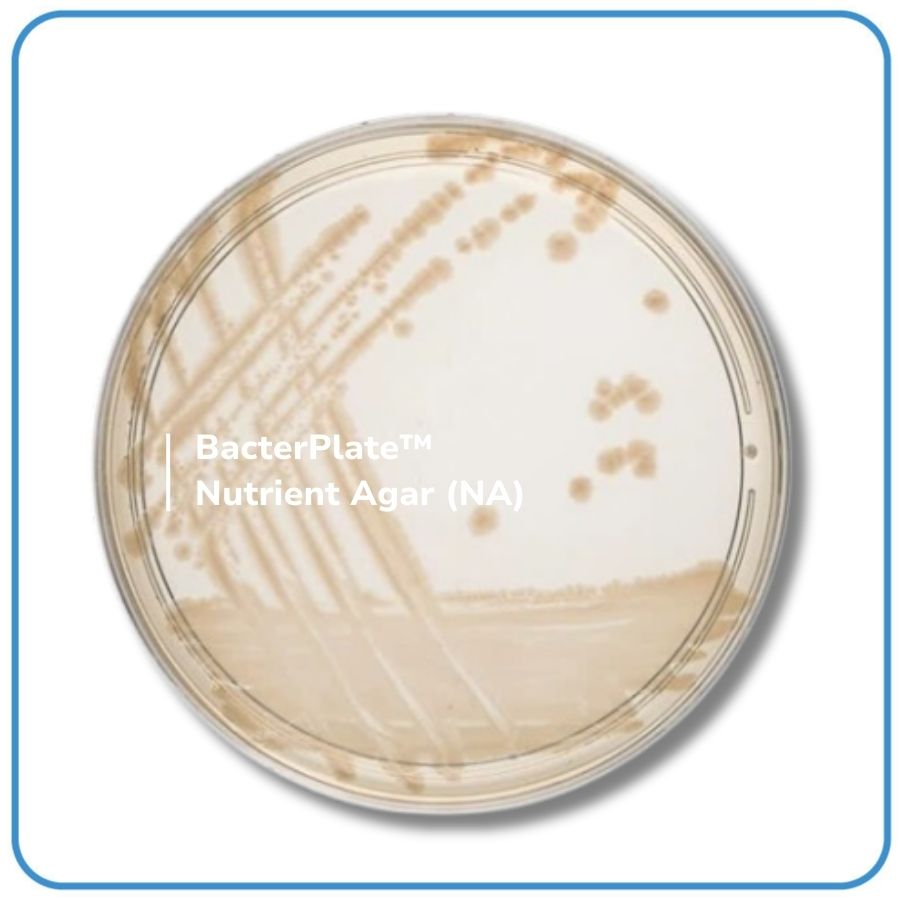

INTENDED USE
- BacterPlate™ Nutrient Agar (NA) is used in food microbiology, in water testing and in animal health for the culture of a wide variety of microorganisms. It is used for colony purification, a critical step in the protocols of identification in many standards. It is suitable for the culture of bacteria that have no particular nutritional requirements.
- The packaging with semi-permeable Cellophane film helps balance the humidity of the environment during storage.
PRINCIPLES
- Relatively simple, the formula supplies the nutritive elements required for the growth of a wide variety of nonfastidious microorganisms.

Tiếng Việt